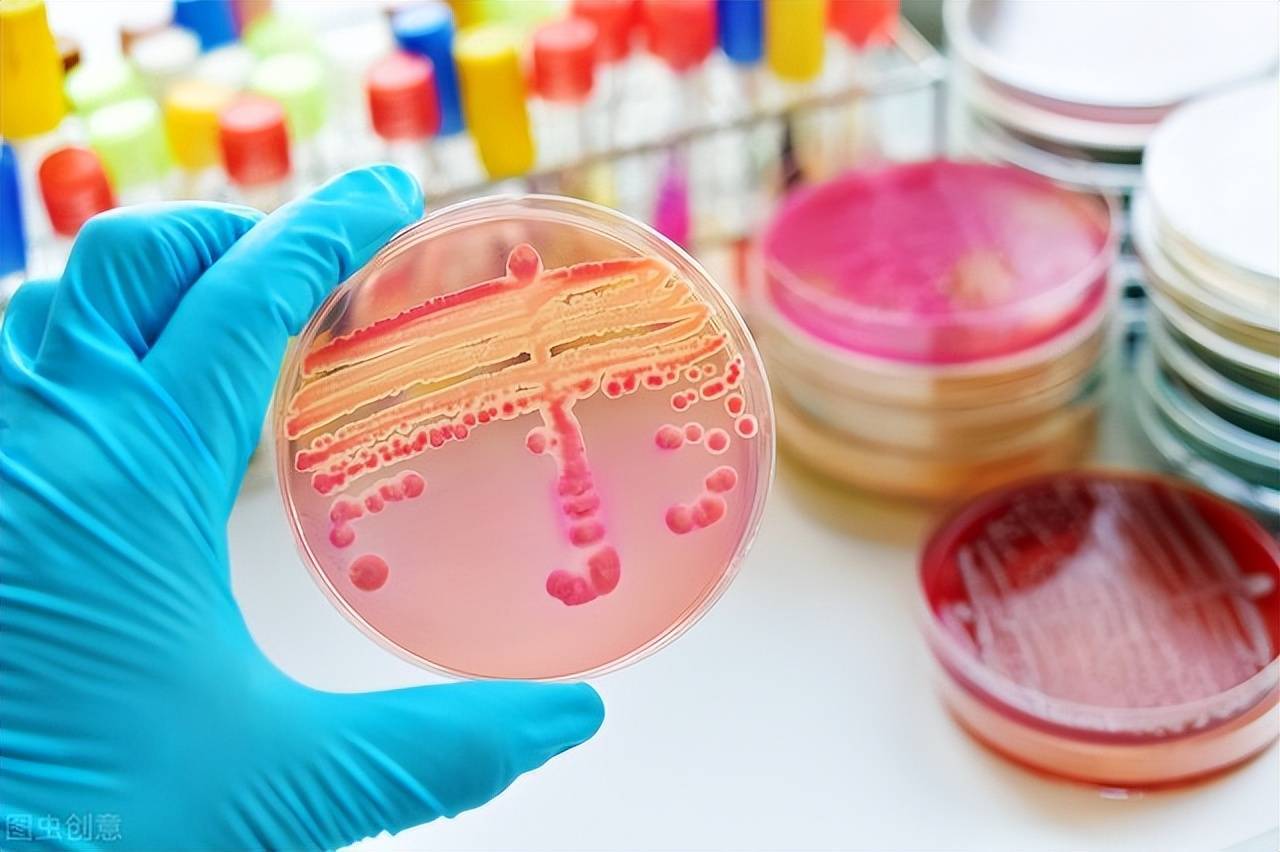
4,小结抗菌纺织品具有广阔的市场发展前景,其对提高卫生健康水平和

抗菌纺织品

河北华恩纺织品制造有限公司a类抗菌长绒棉浴巾素色纯棉男士女士
图片尺寸800x800
河北华恩纺织品制造有限公司a类抗菌长绒棉浴巾素色纯棉男士女士
图片尺寸800x800
耐磨防紫外抗菌纺织品这些功能都可以用它来实现
图片尺寸498x389
一文读懂抗菌纺织品:甲壳素纤维,铜离子纤维,板蓝根纤维,茶纤维,抗菌
图片尺寸1080x547
佳达泰纺织品.yd1684 原纱吸排竹炭纤维双面布抗菌防臭 - 抖音
图片尺寸1440x1440
抗菌纺织品检测标准分析_机构_测试_能力
图片尺寸1000x669
河北华恩纺织品制造有限公司a类抗菌长绒棉浴巾素色纯棉男士女士
图片尺寸800x800
抗菌纺织品
图片尺寸750x500
河北华恩纺织品制造有限公司a类抗菌长绒棉浴巾素色纯棉男士女士
图片尺寸800x800
河北华恩纺织品制造有限公司春夏纯棉a类新疆长绒棉毛巾素色抗菌
图片尺寸800x800
一文读懂抗菌纺织品甲壳素纤维铜离子纤维板蓝根纤维茶纤维抗菌粘胶
图片尺寸550x412
生活中常见的抗菌纺织品,你知道都是如何生产的吗?_纤维_整理_方法
图片尺寸1080x720
河北华恩纺织品制造有限公司春夏纯棉a类新疆长绒棉毛巾素色抗菌
图片尺寸800x800
科普抗菌纺织品的加工发展和应用
图片尺寸1080x577
4,小结抗菌纺织品具有广阔的市场发展前景,其对提高卫生健康水平和
图片尺寸1280x852
河北华恩纺织品制造有限公司春夏纯棉a类新疆长绒棉毛巾素色抗菌
图片尺寸310x310
什么是抗菌纺织品深度剖析抗菌面料和织物银离子抗菌剂
图片尺寸660x482
除了抗菌功能,还有这些你没见过的多功能纺织品
图片尺寸1080x720
市场新宠——抗菌功能纺织品
图片尺寸640x640
河北华恩纺织品制造有限公司a类抗菌长绒棉浴巾素色纯棉男士女士
图片尺寸291x310